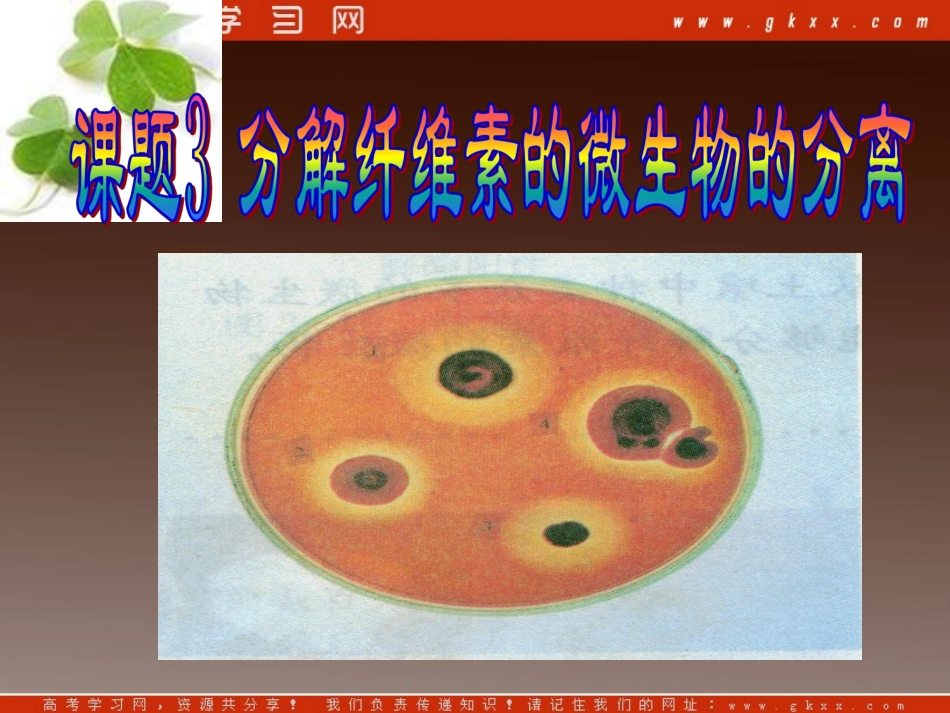
高中生物《第二章 第三节 分解纤维素的微生物的分离》课件2 (新人教版选修1)_第3页

纤维素:棉花是自然界中纤维素含量最高的天然产物;纤维素是地球上含量最丰富的多糖类物质,植物每年产生的纤维素超过70亿吨;分布植物的根、茎、叶中;1、在草食性动物等的消化道内,也共生有分解纤维素的微生物,其原理也是产生纤维素酶而分解纤维素,而人没有分解纤维素的能力
2、农作物秸秆::米秸、麦秸、稻草、草、木屑米秸、麦秸、稻草、草、木屑等富含大量的纤维素,被利用的机会很少、效率低;纤维素生物燃料:最有希望替代石油能源科学家正致力于研究,怎样将农业废弃物、木材及生长更为迅速的草本植物,转化为种类繁多的生物燃料(甚至是航空燃油)
一、基础知识1
纤维纤维素素纤维素是一种由纤维素是一种由葡萄糖葡萄糖首尾相连而成首尾相连而成的的高分子高分子化合物,是含量最丰富的化合物,是含量最丰富的多糖多糖类物质
土壤中某些微生物能够产生土壤中某些微生物能够产生纤维素酶,,把纤维素分解为葡萄糖,后再利用把纤维素分解为葡萄糖,后再利用
纤维素酶纤维素酶纤维素酶是一种纤维素酶是一种复合酶复合酶,一般认为它,一般认为它至少包至少包括三种组分括三种组分,即,即CC11酶酶((外切酶外切酶))、、CCXX酶酶((内切内切酶酶))和葡萄糖苷酶和葡萄糖苷酶,前两种酶使纤维素分解成,前两种酶使纤维素分解成纤维二糖,第三种酶将纤维二糖分解成葡萄糖
纤维二糖,第三种酶将纤维二糖分解成葡萄糖
纤维二糖C1酶、Cx酶葡萄糖苷酶葡萄糖纤维素一、基础知识在2支20mL的试管中,分别放入1×6cm的滤纸条,再分别加入pH为4
8、物质的量浓度为0
1mol/L的醋酸-醋酸钠缓冲液10mL、11mL
在加入10mL缓冲液的试管中加入1mL纤维素酶(70~80U/mL)
将二支试管固定在50mL的锥形瓶中,在摇床上以140r/min的转速振荡反应1h,观察结果
1U表示1个酶活力单位,是指在温度为25℃,其他反应